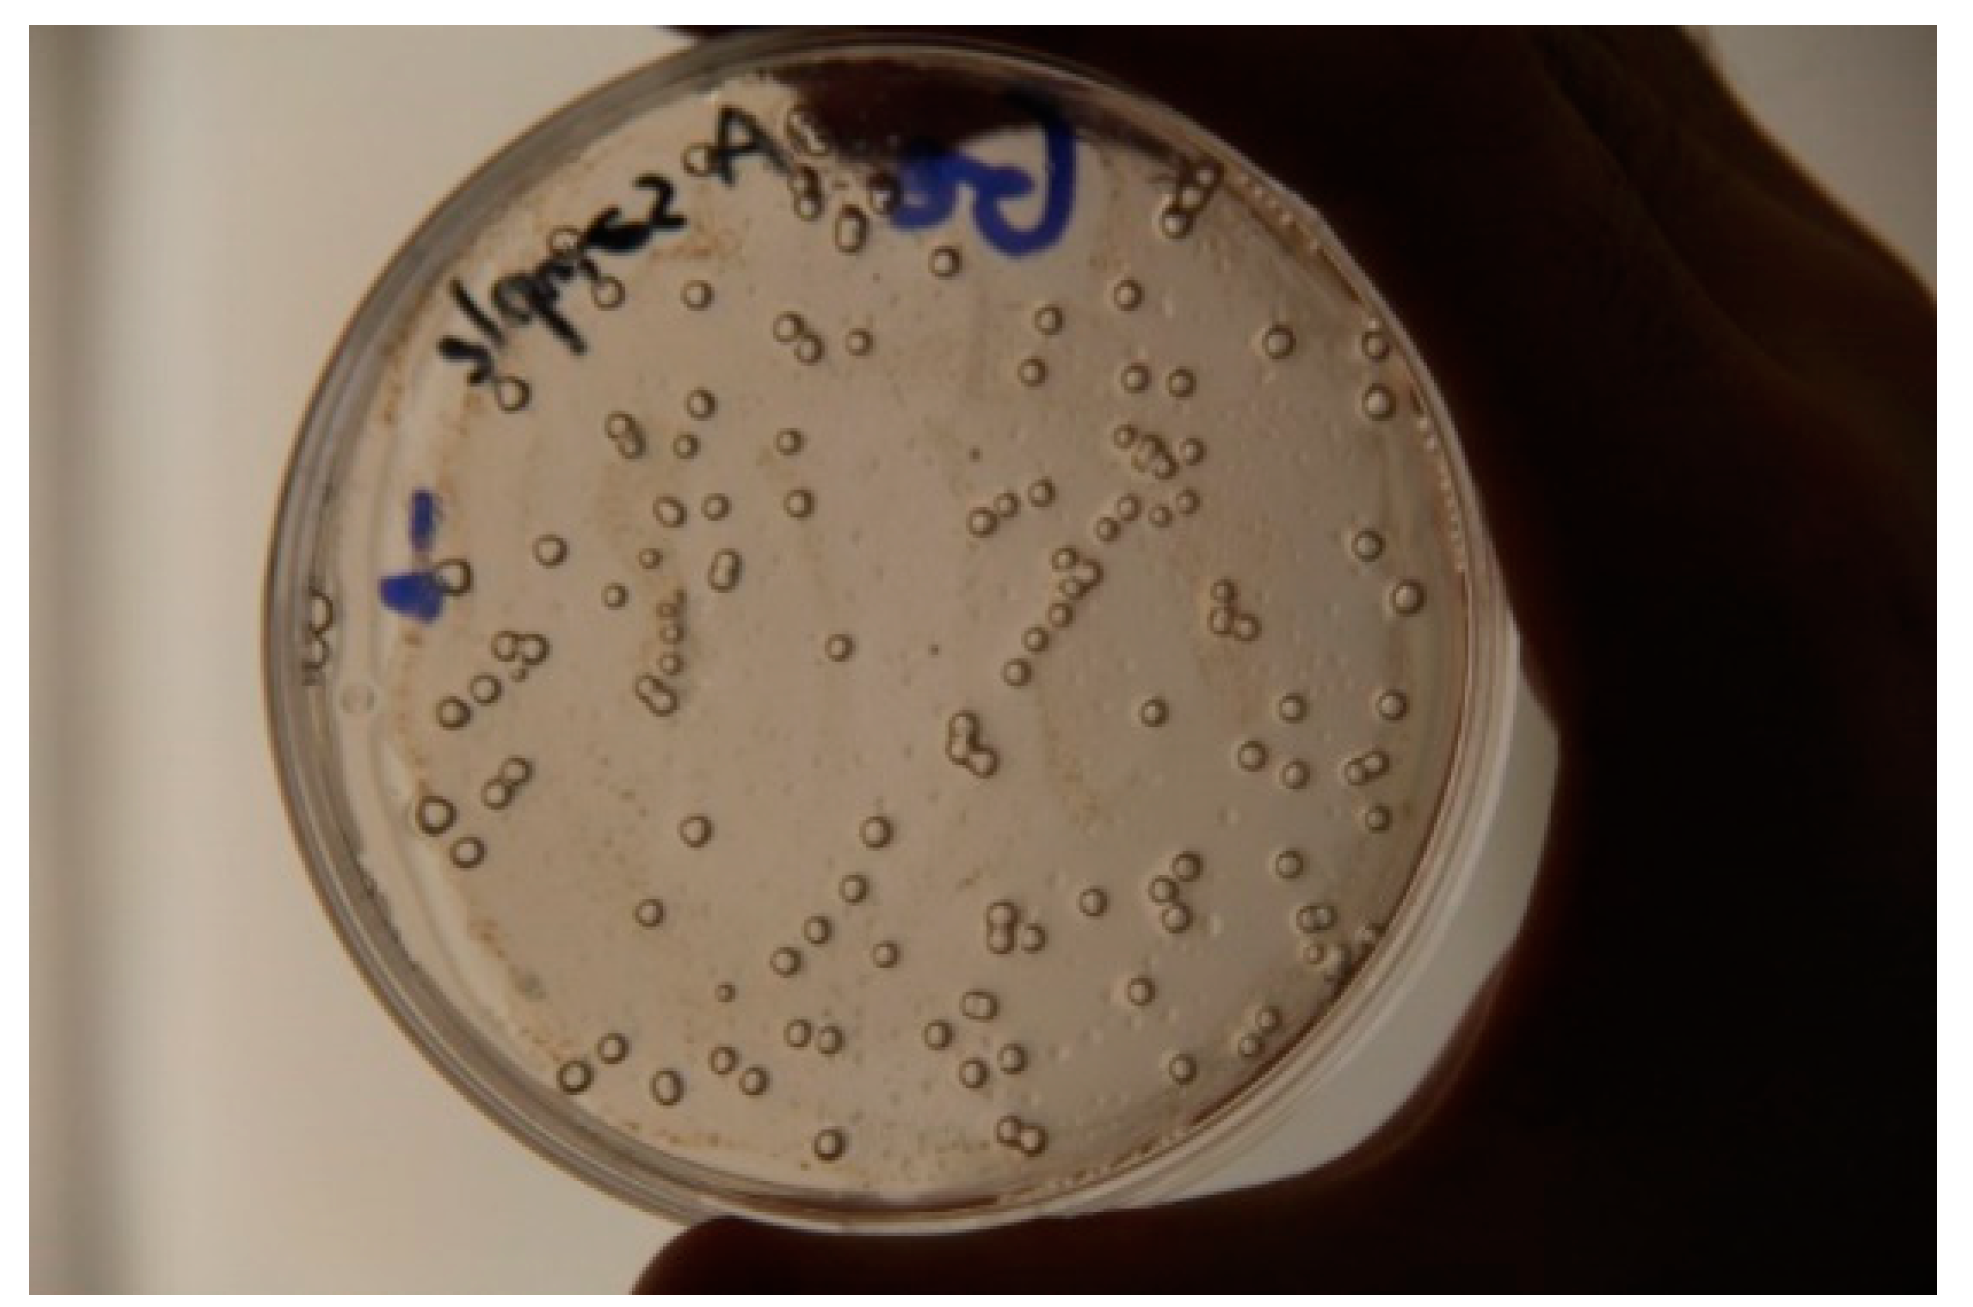
Water 13 01533 g003 Water 13 01533 g003

Cultivation and Molecular Studies to Reveal the Microbial Communities of Groundwaters Discharge Located in Hungary
Abstract
1. Introduction
2. Materials and Methods
2.1. Description of the Hydro-Geological Properties of the Sampling Sites
2.2. Collection of Water Sample
2.3. Determination of the Physical and Chemical Parameters
2.4. Determination of Total Cell Count
2.5. Isolation of Bacterial Strains
2.6. Molecular Analysis
2.6.1. DNA Isolation and Identification of the Isolated Bacterial Strains
2.6.2. DNA Extraction from the Water Samples and Amplicon Sequencing
2.7. Study of the Bacterial Growth in Different Media
2.8. Statistical Analyses
3. Results
3.1. Physical and Chemical Parameters of the Water Samples
3.2. Microscopic Cell Counts and Diversity Indices of the Samples
3.3. Bacterial Community Composition of the Different Samples Based on Amplicon Sequencing
3.4. Archaeal Community Composition of the Different Samples Based on Amplicon Sequencing
3.5. Results of Cultivation
3.6. Results of Bacterial Growth in Different Concentrations of Media
4. Discussion
4.1. Influence of the Environmental Factors to the Diversity of Archaeal and Bacterial Communities
4.2. Microbial Communities of the Different Samples Based on Amplicon Sequencing
4.3. Cultivable Bacterial Communities of the Samples
4.4. Growth of the Bacterial Strains in Different Concentrations of Media
5. Conclusions
Supplementary Materials
Author Contributions
Funding
Institutional Review Board Statement
Informed Consent Statement
Data Availability Statement
Acknowledgments
Conflicts of Interest
References
- Cavicchioli, R.; Ostrowski, M.; Fegatella, F.; Goodchild, A.; Guixa-Boixereu, N. Life under Nutrient Limitation in Oligotrophic Marine Environments: An Eco/Physiological Perspective of Sphingopyxis alaskensis (formerly Sphingomonas alaskensis). Microb. Ecol. 2003, 46, 249–256. [Google Scholar] [CrossRef]
- Kuznetsov, S.I.; Dubinina, G.A.; Lapteva, N.A. Biology of Oligotrophic Bacteria. Annu. Rev. Microbiol. 1979, 33, 377–387. [Google Scholar] [CrossRef]
- Barer, M.; Harwood, C.R. Bacterial Viability and Culturability. Adv. Microb. Physiol. 1999, 41, 93–137. [Google Scholar] [CrossRef] [PubMed]
- Lengeler, J.W.; Drews, G.; Schlegel, H.G. Biology of the Prokaryotes; Thieme: New York, NY, USA, 1999. [Google Scholar]
- Flynn, T.M.; Sanford, R.A.; Ryu, H.; Bethke, C.M.; Levine, A.D.; Ashbolt, N.J.; Domingo, J.W.S. Functional Microbial Diversity Explains Groundwater Chemistry in a Pristine Aquifer. BMC Microbiol. 2013, 13, 146. [Google Scholar] [CrossRef]
- Basler, B.L.; Losick, R. Bacterially speaking. Cell 2006, 125, 237–246. [Google Scholar] [CrossRef]
- Legan, J.D.; Owens, J.D. Bacterial competition for methylamine: Computer simulation of a three-strain continuous culture supplied continuously or alternatively with two nutrients. FEMS Microbiol. Ecol. 1988, 53, 307–314. [Google Scholar] [CrossRef]
- Ho, A.; Di Lonardo, P.; Bodelier, P.L.E. Revisiting life strategy concepts in environmental microbial ecology. FEMS Microbiol. Ecol. 2017, 93, 1–14. [Google Scholar] [CrossRef]
- Andrés, M.; Gil, R.; Latorre, A.; Peretó, J.; Garcillán-Barcia, M.P.; De La Cruz, F. Toward Minimal Bacterial Cells: Evolution vs. Design. FEMS Microbiol. Rev. 2009, 33, 225–235. [Google Scholar]
- Dombrowski, N.; Lee, J.-H.; Williams, T.; Offre, P.; Spang, A. Genomic diversity, lifestyles and evolutionary origins of DPANN archaea. FEMS Microbiol. Lett. 2019, 366, 1–12. [Google Scholar] [CrossRef] [PubMed]
- Phung, N.T.; Jiyoung, L.; Kui, H.K.; In Seop, C.; Geoffrey, M.G.; Byung, H.K. Analysis of Microbial Diversity in Oligotrophic Microbial Fuel Cells Using 16S RDNA Sequences. FEMS Microbiol. Lett. 2004, 233, 77–82. [Google Scholar] [CrossRef] [PubMed]
- Hayakawa, D.H.; Huggett, M.J.; Rappé, M.S. Ecology and Cultivation of Marine Oligotrophic Bacteria. In Extremophiles Handbook; Springer Science and Business Media LLC: Berlin/Heidelberg, Germany, 2011; pp. 1161–1178. [Google Scholar]
- Kaeberlein, T.; Lewis, K.; Epstein, S.S. Isolating “uncultivable” microorganisms in pure culture in a simulated natural envi-ronment. Science 2002, 296, 1127–1129. [Google Scholar] [CrossRef] [PubMed]
- Janssen, P.H.; Yates, P.S.; Grinton, B.E.; Taylor, P.M.; Sait, M. Improved Culturability of Soil Bacteria and Isolation in Pure Culture of Novel Members of the Divisions Acidobacteria, Actinobacteria, Proteobacteria, and Verrucomicrobia. Appl. Environ. Microbiol. 2002, 68, 2391–2396. [Google Scholar] [CrossRef] [PubMed]
- Rappé, M.S.; Connon, S.A.; Vergin, K.L.; Giovannoni, S.J. Cultivation of the ubiquitous SAR11 marine bacterioplankton clade. Nat. Cell Biol. 2002, 418, 630–633. [Google Scholar] [CrossRef]
- Braun, B.; Schröder, J.; Knecht, H.; Szewzyk, U. Unraveling the Microbial Community of a Cold Groundwater Catchment System. Water Res. 2016, 07, 113–126. [Google Scholar] [CrossRef] [PubMed]
- Erőss, A.; Mádl-Szőnyi, J.; Csoma, A.É. Characteristics of discharge at Rose and Gellért Hills, Budapest, Hungary. Cent. Eur. Geol. 2008, 51, 267–281. [Google Scholar] [CrossRef]
- Jobbágy, V.; Kávási, N.; Somlai, J.; Dombovári, P.; Gyöngyösi, C.; Kovács, T. Gross Alpha and Beta Activity Concentrations in Spring Waters in Balaton Upland, Hungary. Radiat. Measur. 2011, 46, 159–163. [Google Scholar] [CrossRef]
- Mádl-Szőnyi, J.; Tóth, Á. Basin-scale conceptual groundwater flow model for an unconfined and confined thick carbonate region. Hydrogeol. J. 2015, 23, 1359–1380. [Google Scholar] [CrossRef]
- Izápy, G. Magyarország forrásainak katasztere. In Budapest, VITUKI Hydrological Institute; Natural Spring Cadastre of Hungary: Berlin/Heidelberg, Germany, 2002. (In Hungarian) [Google Scholar]
- Emese, G.; Tóth, G. In cooperation with SGUDS, Transboundary Geothermal, and Energy Resources. In Report on Komárom—Štúrovo Pilot Area Scenario Modeling; Slovakia, 2013; Available online: http://transenergy-eu.geologie.ac.at/Downloads/outputs/Scenario%20model%20report/WP5_5.3_Komarno-Sturovo%20pilot%20area%20scenario%20modeling.pdf (accessed on 7 November 2004).
- Rice, E.W.; Baird, R.B.; Eaton, A.D. Standard Methods for the Examination of Water and Wastewater, 23rd ed.; American Public Health Association, American Water Works Association, Water Environment Federation: Washington, DC, USA, 2017; ISBN 9780875532875. [Google Scholar]
- Kéki, Z.; Makk, J.; Barkács, K.; Vajna, B.; Palatinszky, M.; Márialigeti, K.; Tóth, E. Critical point analysis and biocide treatment in a microbiologically contaminated water purification system of a power plant. SN Appl. Sci. 2019, 1, 820. [Google Scholar] [CrossRef]
- Szuróczki, S.; Kéki, Z.; Káli, S.; Lippai, A.; Márialigeti, K.; Tóth, E. Microbiological investigations on the water of a thermal bath at Budapest. Acta Microbiol. Immunol. Hung. 2016, 63, 229–241. [Google Scholar] [CrossRef] [PubMed]
- Carbonnelle, E.; Mesquita, C.; Bille, E.; Day, N.; Dauphin, B.; Beretti, J.-L.; Ferroni, A.; Gutmann, L.; Nassif, X. MALDI-TOF mass spectrometry tools for bacterial identification in clinical microbiology laboratory. Clin. Biochem. 2011, 44, 104–109. [Google Scholar] [CrossRef]
- Kalwasińska, A.; Felföldi, T.; Walczak, M.; Kosobucki, P. Physiology and Molecular Phylogeny of Bacteria Isolated from Alka-line Distillery Lime. Pol. J. Microbiol. 2015, 64, 369–377. [Google Scholar] [CrossRef]
- Yoon, S.H.; Sung, M.H.; Soonjae, K.; Jeongmin, L.; Yeseul, K.; Hyungseok, S.; Jongsik, C. Introducing EzBioCloud: A Taxo-nomically United Database of 16S RRNA Gene Sequences and Whole-Genome Assemblies. Int. J. Sys. Evol. Microbiol. 2017, 67, 1613–1617. [Google Scholar] [CrossRef] [PubMed]
- Herlemann, D.P.R.; Labrenz, M.; Jürgens, K.; Bertilsson, S.; Waniek, J.J.; Andersson, A.F. Transitions in bacterial communities along the 2000 km salinity gradient of the Baltic Sea. ISME J. 2011, 5, 1571–1579. [Google Scholar] [CrossRef] [PubMed]
- Klindworth, A.; Pruesse, E.; Schweer, T.; Peplies, J.; Quast, C.; Horn, M.; Glöckner, F.O. Evaluation of general 16S ribosomal RNA gene PCR primers for classical and next-generation sequencing-based diversity studies. Nucleic Acids Res. 2012, 41, e1. [Google Scholar] [CrossRef] [PubMed]
- Schloss, P.D.; Westcott, S.L.; Ryabin, T.; Hall, J.R.; Hartmann, M.; Hollister, E.B.; Lesniewski, R.A.; Oakley, B.B.; Parks, D.H.; Robinson, C.J.; et al. Introducing mothur: Open-Source, Platform-Independent, Community-Supported Software for Describing and Comparing Microbial Communities. Appl. Environ. Microbiol. 2009, 75, 7537–7541. [Google Scholar] [CrossRef] [PubMed]
- Quast, C.; Pruesse, E.; Yilmaz, P.; Gerken, J.; Schweer, T.; Yarza, P.; Peplies, J.; Glöckner, F.O. The SILVA Ribosomal RNA Gene Database Project: Improved Data Processing and Web-Based Tools. Nucleic Acids Res. 2013, 41, 590–596. [Google Scholar] [CrossRef]
- Edgar, R.C.; Haas, B.J.; Clemente, J.C.; Quince, C.; Knight, R. UCHIME Improves Sensitivity and Speed of Chimera Detection. Bioinformatics 2011, 27, 2194–2200. [Google Scholar] [CrossRef] [PubMed]
- Reasoner, D.J.; Geldreich, E.E. A new medium for the enumeration and subculture of bacteria from potable water. Appl. Environ. Microbiol. 1985, 49, 1–7. [Google Scholar] [CrossRef] [PubMed]
- Oksanen, J.; Blanchet, F.G.; Kindt, R.; Legendre, P.; Minchin, P.R.; O’Hara, R.; Simpson, G.L.; Solymos, P.; Stevens, M.H.H.; Wagner, H. Ordination Methods, Diversity Analysis and Other Functions for Community and Vegetation Ecologists, 2020, Vegan: Community Ecology Package. Available online: https://cran.r-project.org/package=vegan (accessed on 29 May 2021).
- Lemos, L.N.; Fulthorpe, R.R.; Triplett, E.W.; Roesch, L.F. Rethinking microbial diversity analysis in the high throughput sequencing era. J. Microbiol. Methods 2011, 86, 42–51. [Google Scholar] [CrossRef]
- Giovannoni, S.J.; Britschgi, T.B.; Moyer, C.L.; Field, K.G. Genetic diversity in Sargasso Sea bacterioplankton. Nat. Cell Biol. 1990, 345, 60–63. [Google Scholar] [CrossRef]
- Herrmann, M.; Wegner, C.-E.; Taubert, M.; Geesink, P.; Lehmann, K.; Yan, L.; Lehmann, R.; Totsche, K.U.; Küsel, K. Predominance of Cand. Patescibacteria in Groundwater Is Caused by Their Preferential Mobilization from Soils and Flourishing Under Oligotrophic Conditions. Front. Microbiol. 2019, 10, 1407. [Google Scholar] [CrossRef]
- Mazzullo, S. Organogenic Dolomitization in Peritidal to Deep-Sea Sediments: PERSPECTIVES. J. Sediment. Res. 2000, 70, 10–23. [Google Scholar] [CrossRef]
- Roberts, J.A.; Kenward, P.A.; Fowle, D.; Goldstein, R.H.; González, L.A.; Moore, D.S. Surface chemistry allows for abiotic precipitation of dolomite at low temperature. Proc. Natl. Acad. Sci. USA 2013, 110, 14540–14545. [Google Scholar] [CrossRef]
- Perras, A.K.; Daum, B.; Ziegler, C.; Takahashi, L.K.; Musahid, A.; Wanner, G.; Klingl, A.; Leitinger, G.; Kolb-Lenz, D.; Gribaldo, S.; et al. S-Layers at Second Glance? Altiar-chaeal Grappling Hooks (Hami) Resemble Archaeal S-Layer Proteins in Structure and Sequence. Front. Microbiol. 2015, 6, 543. [Google Scholar] [CrossRef] [PubMed]
- Lopez-Fernandez, M.; Åström, M.; Bertilsson, S.; Dopson, M. Depth and Dissolved Organic Carbon Shape Microbial Com-munities in Surface Influenced but Not Ancient Saline Terrestrial Aquifers. Front. Microbiol. 2018, 9, 1–16. [Google Scholar] [CrossRef]
- Liu, X.; Li, M.; Castelle, C.J.; Probst, A.J.; Zhou, Z.; Pan, J.; Liu, Y.; Banfield, J.F.; Gu, J.-D. Insights into the ecology, evolution, and metabolism of the widespread Woesearchaeotal lineages. Microbiome 2018, 6, 1–16. [Google Scholar] [CrossRef] [PubMed]
- Lau, M.C.Y.; Kieft, T.L.; Kuloyo, O.; Linage-Alvarez, B.; van Heerden, E.; Lindsay, M.R.; Magnabosco, C.; Wang, W.; Wiggins, J.B.; Guo, L.; et al. An oligotrophic deep-subsurface community dependent on syntrophy is dominated by sulfur-driven autotrophic denitrifiers. Proc. Natl. Acad. Sci. USA 2016, 113, E7927–E7936. [Google Scholar] [CrossRef]
- Kasper, S.A.; Kirkegaard, R.H.; Karst, S.M.; Albertsen, M. ampvis2: An R package to analyse and visualise 16S rRNA amplicon data. bioRxiv 2018, 299537. [Google Scholar] [CrossRef]
- Liu, X.; Wang, Y.; Gu, J.-D. Ecological distribution and potential roles of Woesearchaeota in anaerobic biogeochemical cycling unveiled by genomic analysis. Comput. Struct. Biotechnol. J. 2021, 19, 794–800. [Google Scholar] [CrossRef]
- Bruno, A.; Sandionigi, A.; Bernasconi, M.; Panio, A.; Labra, M.; Casiraghi, M. Changes in the Drinking Water Microbiome: Effects of Water Treatments along the Flow of Two Drinking Water Treatment Plants in a Urbanized Area, Milan (Italy). Front. Microbiol. 2018, 9, 2557. [Google Scholar] [CrossRef] [PubMed]
- Probst, A.J.; Weinmaier, T.; Raymann, K.; Perras, A.K.; Emerson, J.B.; Rattei, T.; Wanner, G.; Klingl, A.; Berg, I.A.; Yoshinaga, M.Y.; et al. Biology of a widespread uncultivated archaeon that contributes to carbon fixation in the subsurface. Nat. Commun. 2014, 5, 5497. [Google Scholar] [CrossRef]
- Rudolph, C.; Moissl, C.; Henneberger, R.; Huber, R. Ecology and microbial structures of archaeal/bacterial strings-of-pearls communities and archaeal relatives thriving in cold sulfidic springs. FEMS Microbiol. Ecol. 2004, 50, 1–11. [Google Scholar] [CrossRef] [PubMed]
- Oh, S.; Donggeon, C. Microbial Community Enhances Biodegradation of Bisphenol A through Selection of Sphingomona-daceae. Microb. Ecol. 2019, 77, 631–639. [Google Scholar] [CrossRef] [PubMed]
- Táncsics, A.; Szalay, A.R.; Farkas, M.; Benedek, T.; Szoboszlay, S.; Szabó, I.; Lueders, T. Stable isotope probing of hypoxic toluene degradation at the Siklós aquifer reveals prominent role of Rhodocyclaceae. FEMS Microbiol. Ecol. 2018, 94, 1–11. [Google Scholar] [CrossRef] [PubMed]
- Frank, Y.A.; Kadnikov, V.V.; Lukina, A.P.; Banks, D.; Beletsky, A.V.; Mardanov, A.V.; Sen’kina, E.I.; Avakyan, M.R.; Karnachuk, O.V.; Ravin, N.V. Characterization and Genome Analysis of the First Facultatively Alkaliphilic Thermodesul-fovibrio Isolated from the Deep Terrestrial Subsurface. Front. Microbiol. 2016, 7, 1–11. [Google Scholar] [CrossRef] [PubMed]
- Probst, A.J.; Castelle, C.J.; Singh, A.; Brown, C.T.; Anantharaman, K.; Sharon, I.; Hug, L.A.; Burstein, D.; Emerson, J.B.; Thomas, B.C.; et al. Genomic resolution of a cold subsurface aquifer community provides metabolic insights for novel microbes adapted to high CO2concentrations. Environ. Microbiol. 2017, 19, 459–474. [Google Scholar] [CrossRef]
- Zhou, L.; Wang, S.; Zou, Y.; Xia, C.; Zhu, G. Species, Abundance and Function of Ammonia-oxidizing Archaea in Inland Waters across China. Sci. Rep. 2015, 5, 15969. [Google Scholar] [CrossRef] [PubMed]
- Yi, H.; Chun, J. Flavobacterium weaverense sp. nov. and Flavobacterium segetis sp. nov., novel psychrophiles isolated from the Antarctic. Int. J. Syst. Evol. Microbiol. 2006, 56, 1239–1244. [Google Scholar] [CrossRef]
- Jean-François, B.; Bowman, J.P. Flavobacterium; Bergey’s Manual of Systematics of Archaea and Bacteria: New Jersey, NJ, USA, 2015; pp. 1–75. [Google Scholar]
- Bräuer, S.; Cadillo-Quiroz, H.; Kyrpides, N.; Woyke, T.; Goodwin, L.; Detter, C.; Podell, S.; Yavitt, J.B.; Zinder, S.H. Genome of Methanoregula boonei 6A8 reveals adaptations to oligotrophic peatland environments. Microbiology 2015, 161, 1572–1581. [Google Scholar] [CrossRef]
- Danczak, R.E.; Johnston, M.D.; Kenah, C.; Slattery, M.; Wrighton, K.C.; Wilkins, M.J. Members of the Candidate Phyla Radiation are functionally differentiated by carbon- and nitrogen-cycling capabilities. Microbiome 2017, 5, 112. [Google Scholar] [CrossRef]
- Strous, M.; Van Gerven, E.; Gijs, J.K.; Jetten, M. Effects of Aerobic and Microaerobic Conditions on Anaerobic Ammonium- Oxidizing (Anammox) Sludge. Appl. Environ. Microbiol. 1997, 63, 2446–2448. [Google Scholar] [CrossRef] [PubMed]
- Nelson, W.C.; Stegen, J.C. The reduced genomes of Parcubacteria (OD1) contain signatures of a symbiotic lifestyle. Front. Microbiol. 2015, 6, 713. [Google Scholar] [CrossRef] [PubMed]
- Anantharaman, K.; Brown, C.T.; Burstein, D.; Castelle, C.J.; Probst, A.J.; Thomas, B.C.; Williams, K.H.; Banfield, J.F. Analysis of Five Complete Genome Sequences for Members of the Class Peribacteria in the Recently Recognized Peregrinibacteria Bac-terial Phylum. Peer J. 2016, 1, 1–14. [Google Scholar]
- Lemos, L.N.; Medeiros, J.D.; Dini-Andreote, F.; Fernandes, G.R.; Varani, A.D.M.; Oliveira, G.; Pylro, V.S. Genomic signatures and co-occurrence patterns of the ultra-small Saccharimonadia (phylum CPR/Patescibacteria) suggest a symbiotic lifestyle. Mol. Ecol. 2019, 28, 4259–4271. [Google Scholar] [CrossRef]
- Guerrero-Cruz, S.; Cremers, G.; Van Alen, T.A.; Camp, H.O.D.; Jetten, M.S.M.; Rasigraf, O.; Vaksmaa, A. Response of the Anaerobic Methanotroph “CandidatusMethanoperedens nitroreducens” to Oxygen Stress. Appl. Environ. Microbiol. 2018, 84, 1–17. [Google Scholar] [CrossRef]
- Gayner, N.J. River Bank Inducement Influence on a Shallow Groundwater Microbial Community and Its Effects on Aquifer Reactivity. Master’s Thesis, University of Wisconsin-Milwaukee, Milwaukee, WI, USA, 2018. [Google Scholar]
- Fernandes, G.L.; Shenoy, B.D.; Damare, S.R. Diversity of Bacterial Community in the Oxygen Minimum Zones of Arabian Sea and Bay of Bengal as Deduced by Illumina Sequencing. Front. Microbiol. 2020, 10, 1–14. [Google Scholar] [CrossRef]
- Zemskaya, T.I.; Bukin, S.V.; Zakharenko, A.S.; Chernitsyna, S.M.; Shubenkova, O.V. Microbial communities in the estuarine water areas of the rivers in the southeastern part of Lake Baikal. Limnol. Freshw. Biol. 2019, 4, 259–265. [Google Scholar] [CrossRef]
- Takai, K.; Moser, D.P.; DeFlaun, M.; Onstott, T.C.; Fredrickson, J.K. Archaeal Diversity in Waters from Deep South African Gold Mines. Appl. Environ. Microbiol. 2001, 67, 5750–5760. [Google Scholar] [CrossRef]
- Zhou, Z.; Liu, Y.; Lloyd, K.G.; Pan, J.; Yang, Y.; Gu, J.-D.; Li, M. Genomic and transcriptomic insights into the ecology and metabolism of benthic archaeal cosmopolitan, Thermoprofundales (MBG-D archaea). ISME J. 2019, 13, 885–901. [Google Scholar] [CrossRef]
- Inagaki, F.; Marcel, M.M.K.; Tsunogai, U.; Ishibashi, J.I.; Nakamura, K.I.; Treude, T.; Ohkubo, S.; Nakaseama, M.; Gena, K.; Chiba, H.; et al. Microbial Community in a Sediment-Hosted CO2 Lake of the Southern Okinawa Trough Hydrothermal System. In Proceedings of the National Academy of Sciences of the United States of America, Stanford University, Stanford, CA, USA, 21 July 2006; Volume 103, pp. 14164–14169. [Google Scholar]
- McElwain, R.D. Survival and recovery characteristics of Arcobacter butzleri in groundwater microcosms. In Graduate Theses, Dissertations, and Problem Reports; West Virginia University Libraries: Morgantown, WV, USA, 2019. [Google Scholar]
- Waite, D.W.; Vanwonterghem, I.; Rinke, C.; Parks, D.H.; Zhang, Y.; Takai, K.; Sievert, S.M.; Simon, J.; Campbell, B.J.; Hanson, T.E.; et al. Comparative Genomic Analysis of the Class Epsilonproteobacteria and Proposed Reclassification to Epsilonbacteraeota (phyl. nov.). Front. Microbiol. 2017, 8, 682. [Google Scholar] [CrossRef] [PubMed]
- Stöhr, R.; Waberski, A.; Liesack, W.; Völker, H.; Wehmeyer, U.; Thomm, M. Hydrogenophilus Hirschii Sp. Nov., a Novel Thermophilic Hydrogen-Oxidizing β-Proteobacterium Isolated from Yellowstone National Park. Int. J. Syst. Evol. Microbiol. 2001, 51, 481–488. [Google Scholar] [CrossRef]
- Vésteinsdóttir, H.; Reynisdóttir, D.B.; Örlygsson, J. Hydrogenophilus islandicus sp. nov., a thermophilic hydrogen-oxidizing bacterium isolated from an Icelandic hot spring. Int. J. Syst. Evol. Microbiol. 2011, 61, 290–294. [Google Scholar] [CrossRef] [PubMed][Green Version]
- Han, Y.; Perner, M. The Role of Hydrogen for Sulfurimonas denitrificans’ Metabolism. PLoS ONE 2014, 9, e106218. [Google Scholar] [CrossRef] [PubMed]
- Cai, L.; Shao, M.-F.; Zhang, T. Non-contiguous finished genome sequence and description of Sulfurimonas hongkongensis sp. nov., a strictly anaerobic denitrifying, hydrogen- and sulfur-oxidizing chemolithoautotroph isolated from marine sediment. Stand. Genom. Sci. 2014, 9, 1302–1310. [Google Scholar] [CrossRef]
- Marsden, A.E.; Grudzinski, K.; Ondrey, J.M.; DeLoney-Marino, C.R.; Visick, K.L. Impact of Salt and Nutrient Content on Biofilm Formation by Vibrio fischeri. PLoS ONE 2017, 12, e0169521. [Google Scholar] [CrossRef] [PubMed]
- Mohapatra, B.; Sar, P.; Kazy, S.K.; Maiti, M.K.; Satyanarayana, T. Taxonomy and physiology of Pseudoxanthomonas arseniciresistens sp. nov., an arsenate and nitrate-reducing novel gammaproteobacterium from arsenic contaminated groundwater, India. PLoS ONE 2018, 13, e0193718. [Google Scholar] [CrossRef]
- Gray, D.A.; Dugar, G.; Gamba, P.; Strahl, H.; Jonker, M.J.; Hamoen, L.W. Extreme slow growth as alternative strategy to survive deep starvation in bacteria. Nat. Commun. 2019, 10, 1–12. [Google Scholar] [CrossRef]
- Fitri, F.; Cavicchioli, R. Physiological Responses to Starvation in the Marine Oligotrophic Ultramicrobacterium Sphingomonas sp. Strain RB. Appl. Environ. Microbiol. 2000, 66, 2037–2044. [Google Scholar]
- Barton, H.; Taylor, N.; Kreate, M.; Springer, A.; Oehrle, S.; Bertog, J. The impact of host rock geochemistry on bacterial community structure in oligotrophic cave environments. Int. J. Speleol. 2007, 36, 93–104. [Google Scholar] [CrossRef]
- Zhang, D.; Li, W.; Huang, X.; Qin, W.; Liu, M. Removal of ammonium in surface water at low temperature by a newly isolated Microbacterium sp. strain SFA. Bioresour. Technol. 2013, 137, 147–152. [Google Scholar] [CrossRef] [PubMed]
- Puri, A.; Padda, K.P.; Chanway, C.P. Can naturally-occurring endophytic nitrogen-fixing bacteria of hybrid white spruce sustain boreal forest tree growth on extremely nutrient-poor soils? Soil Biol. Biochem. 2020, 140, 107642. [Google Scholar] [CrossRef]
- Tilak, K.V.B.R.; Ranganayaki, N.; Manoharachari, C. Synergistic effects of plant-growth promoting rhizobacteria and Rhizobium on nodulation and nitrogen fixation by pigeonpea (Cajanus cajan). Eur. J. Soil Sci. 2006, 57, 67–71. [Google Scholar] [CrossRef]
- Rogel, M.A.; Hernandez-Lucas, I.; Kuykendall, L.D.; Balkwill, D.L.; Martínez-Romero, E.; Hernández-Lucas, I. Nitrogen-Fixing Nodules with Ensifer adhaerens Harboring Rhizobium tropici Symbiotic Plasmids. Appl. Environ. Microbiol. 2001, 67, 3264–3268. [Google Scholar] [CrossRef] [PubMed]
- Gonzalez-Martinez, A.; Rodriguez-Sanchez, A.; Garcia-Ruiz, M.J.; Palazon, B.M.; Cortes-Lorenzo, C.; Osorio, F.; Vahala, R. Performance and bacterial community dynamics of a CANON bioreactor acclimated from high to low operational temperatures. Chem. Eng. J. 2016, 287, 557–567. [Google Scholar] [CrossRef]
- Hiraishi, A.; Muramatsu, K.; Ueda, Y. Molecular genetic analyses of Rhodobacter azotoformans sp. nov. and related species of phototrophic bacteria. Syst. Appl. Microbiol. 1996, 19, 168–177. [Google Scholar] [CrossRef]
- Zvb, C. Identification of Heterotrophic Soil Ferrosphere Bacteria and Their Sensitivity to Linuron Pesticide. Sci. Period. Ukr. 2017, 79, 75–87. [Google Scholar]
- Schut, F.; Prins, R.A.; Gottschal, J.C. Isolation and characterisation of the marine ultramicrobacterium Sphingomonas sp. strain RB. FEMS Microbiol. Rev. 1997, 20, 363–369. [Google Scholar] [CrossRef][Green Version]
- Cohen, K.P.S.F.; Kjelleberg, S. Ribosomes Exist in Large Excess over the Apparent Demand for Protein Synthesis during Carbon Starvation in Marine Vibrio sp. strain CCUG 15956. J. Bacteriol. 1992, 174, 6780–6788. [Google Scholar]
- Barton, H.A.; Taylor, M.R.; Pace, N.R. Molecular Phylogenetic Analysis of a Bacterial Community in an Oligotrophic Cave Environment. Geomicrobiol. J. 2004, 21, 11–20. [Google Scholar] [CrossRef]
- Hodgson, D.A. Primary metabolism and its control in streptomycetes: A most unusual group of bacteria. Adv. Microb. Physiol. 2000, 42, 47–238. [Google Scholar] [CrossRef]
- Semenov, A.M. Physiological bases of oligotrophy of microorganisms and the concept of microbial community. Microb. Ecol. 1991, 22, 239–247. [Google Scholar] [CrossRef] [PubMed]
- Chon, K.; Chang, J.-S.; Oh, H.; Lee, E.; Cho, J. Technical Note: Community of bacteria attached on the PVDF MF membrane surface fouled from drinking water treatment, in Seoul, Korea. Drink. Water Eng. Sci. 2009, 2, 35–39. [Google Scholar] [CrossRef][Green Version]
- Yasir, M.; Arooj, K.; Qureshi, I.K.; Fehmida, B.; Mohd, R.; Sher, B.K.; Esam, I.A. Culturomics-Based Taxonomic Diversity of Bacterial Communities in the Hot Springs of Saudi Arabia. OMICS J. Integr. Biol. 2019, 23, 17–27. [Google Scholar] [CrossRef] [PubMed]
- Kalmbach, S.; Manz, W.; Wecke, J.; Szewzyk, U. Aquabacterium gen. nov., with description of Aquabacterium citratiphilum sp. nov., Aquabacterium parvum sp. nov. and Aquabacterium commune sp. nov., three in situ dominant bacterial species from the Berlin drinking water system. Int. J. Syst. Evol. Microbiol. 1999, 49, 769–777. [Google Scholar] [CrossRef] [PubMed]
- Sorokina, A.Y.; Chernousova, E.Y.; Dubinina, G.A. Ferrovibrio denitrificans gen. nov., sp. nov., a novel neutrophilic facultative anaerobic Fe(II)-oxidizing bacterium. FEMS Microbiol. Lett. 2012, 335, 19–25. [Google Scholar] [CrossRef] [PubMed][Green Version]

| Dandár | Szentendre | Szent Flórián | Tatabánya | Ciprián | |
|---|---|---|---|---|---|
| T (°C) | 46 | 8.6 | 11 | 8 | 12.5 |
| pH | 6.70 | 8.09 | 7.89 | 7.01 | 8.10 |
| conductivity (μS/cm) | 1710 | 454 | 388 | 712 | 1205 |
| TOC 1 (mg/L) | 1.75 | 1.97 | 1.81 | 2.40 | 3.40 |
| NO3− (mg/L) | <1.5 | 6.3 | 7.0 | <0.5 | 160 |
| SO42− (mg/L) | 600 | 71 | 83 | 44 | 156 |
| Fe (mg/L) | <0.03 | <0.01 | <0.01 | 0.29 | 33 |
| Hardness CaO (mg/L) | 360 | 5.6 | 11.2 | 234 | 187 |
| Sample | Diversity Index of Archaea | Diversity Index of Bacteria | Cell Counts·mL−1 |
|---|---|---|---|
| Ciprián | 4.56 | 1.95 | 1.33 × 106 |
| Dandár_1 | 1.47 | 3.55 | 7.51 × 105 |
| Dandár_2 | 1.48 | 3.69 | 3.65 × 105 |
| Dandár_3 | 1.59 | 4.59 | 1.74 × 104 |
| Dandár_4 | 1.67 | 4.01 | 4.75 × 104 |
| Szentendre | 6.18 | 8.11 | 1.98 × 104 |
| Szentendre | 5.94 | 7.88 | 5.82 × 104 |
| Szentendre | 5.66 | 7.57 | 1.08 × 105 |
| Szent Flórián_1 | 4.20 | 5.34 | 3.01 × 104 |
| Szent Flórián_2 | 4.07 | 5.71 | 4.59 × 105 |
| Szent Flórián_3 | 4.01 | 4.92 | 3.67 × 105 |
| Tatabánya | 5.52 | 3.55 | 1.33 × 105 |
| Sign of the Bacterial Strain | Closest Relative Based on 16S rRNA Gene Sequencing | Similarity Values (%) |
|---|---|---|
| SG_E_30_P1 | Salinibacterium hongtaonis | 96.33 |
| CG_13_I | Malikia spinosa | 99.81 |
| SA_6_I | Streptomyces umbrinus | 99.04 |
| SA_E_31_P2 | Prosthecobacter algae | 99.62 |
| CG_19_I | Curvibacter delicatus | 99.53 |
| CG_E_13 | Dyadobacter sediminis | 97.23 |
| CG_14_I | Rheinheimera aquatica | 97.97 |
| CG_9_I_P1 | Aquabacterium citratiphilum | 99.53 |
| CA_10_I | Aquabacterium commune | 97.19 |
| SA_E_40 | Ferrovibrio soli | 99.15 |
Publisher’s Note: MDPI stays neutral with regard to jurisdictional claims in published maps and institutional affiliations. |
© 2021 by the authors. Licensee MDPI, Basel, Switzerland. This article is an open access article distributed under the terms and conditions of the Creative Commons Attribution (CC BY) license (https://creativecommons.org/licenses/by/4.0/).
Share and Cite
Toumi, M.; Abbaszade, G.; Sbaoui, Y.; Farkas, R.; Ács, É.; Jurecska, L.; Tóth, E. Cultivation and Molecular Studies to Reveal the Microbial Communities of Groundwaters Discharge Located in Hungary. Water 2021, 13, 1533. https://doi.org/10.3390/w13111533
Toumi M, Abbaszade G, Sbaoui Y, Farkas R, Ács É, Jurecska L, Tóth E. Cultivation and Molecular Studies to Reveal the Microbial Communities of Groundwaters Discharge Located in Hungary. Water. 2021; 13(11):1533. https://doi.org/10.3390/w13111533
Chicago/Turabian StyleToumi, Marwene, Gorkhmaz Abbaszade, Yousra Sbaoui, Rózsa Farkas, Éva Ács, Laura Jurecska, and Erika Tóth. 2021. "Cultivation and Molecular Studies to Reveal the Microbial Communities of Groundwaters Discharge Located in Hungary" Water 13, no. 11: 1533. https://doi.org/10.3390/w13111533
APA StyleToumi, M., Abbaszade, G., Sbaoui, Y., Farkas, R., Ács, É., Jurecska, L., & Tóth, E. (2021). Cultivation and Molecular Studies to Reveal the Microbial Communities of Groundwaters Discharge Located in Hungary. Water, 13(11), 1533. https://doi.org/10.3390/w13111533

